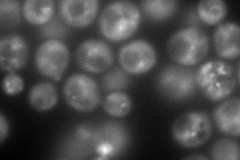
YKR001C
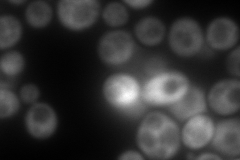
YKR001C
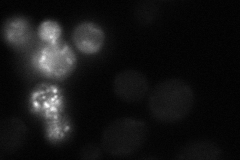
YKR001C
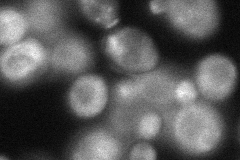
YKR001C
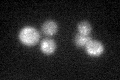
YKR001C

View description
Dynamin-like GTPase required for vacuolar sorting; also involved in actin cytoskeleton organization, late Golgi-retention of some proteins, regulating peroxisome biogenesis
Localization:
Intensity:
Fold change:
Significance:
-
C’ GFP library in SD

punctate16.38 -
N' NOP1pr-GFP in SD
cytosol,punctate206.045 -
N' TEF2pr-mCherry in SD
cytosol,punctate269.532 -
N' NATIVEpr-GFP in SD
punctate21.1751 -
N' TEF2pr-VC and Cyto-VN in SD
cytosol,bud neck62.3679 -
C’ GFP library in SD+DTT
punctate17.631.07No -
C’ GFP library in SD+H2O2

punctate16.511No -
C’ GFP library in Starvation Media

punctate18.911.15No -
C’ GFP library on the background of Pup2-DaMP

punctate -
C’ GFP library on the background of CCT mutant

punctate16.26540.992695No
